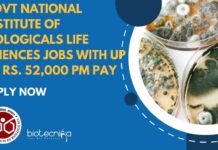
Govt National Institute of Biologicals Life Sciences Jobs With up To Rs. 52,000 pm Pay – Apply Now Govt Life Sciences Jobs at NIB - Applications Invited

Home 2024
Yearly Archives: 2024
AIMMSCR, Amity University Noida – Apply for the Project Assistant Position Now!
AIMMSCR Amity University Noida - Apply for the Project Assistant Position Now!
Applications invited for Project Assistant at AIMMSCR, Amity University Noida - 13-06-2024 -...
NIAB Walk-In-Interview For Life Sciences – Senior Research Fellow Recruitment
NIAB Walk-In-Interview For Life Sciences - Senior Research Fellow Recruitment
National Institute of Animal Biotechnology
(An Autonomous Institute of Dept. of Biotechnology, Ministry of Science &...
Gujarat Biotechnology University In Collaboration With The University of Edinburgh — Admissions 2024 Open...
Gujarat Biotechnology Admissions In Collaboration With The University of Edinburgh — Admissions 2024 Open For MSc Biotechnology Programme
Gujarat Biotechnology University In Collaboration With The...
Govt National Forensic Sciences University Biotech Scientific Officer Recruitment With Rs. 60,200 pm Pay...
Govt Biotech Jobs With Rs. 60,200 pm Pay - Apply Online
Advt No: NFSU/RECRUIT/SCI-STAFF/02/2024 Date 12-06-2024
ENGAGEMENT OF CONTRACTUAL SCIENTIFIC STAFF
National Forensic Sciences University invites application...
Life Sciences Clinical Data Management Specialist Role at Infosys BPM Ltd
Clinical Data Management Specialist Jobs For Life Sciences at Infosys BPM Ltd
Clinical Data Management Specialist
Pune, Maharashtra, India
About the job
Greeting from Infosys BPM Ltd.,
We are...
Avantor R&D Officer Job For MSc Biotech, Microbiology & Life Sciences – Apply Now
Avantor MSc Biotech Job - R&D Officer Vacancy For MSc Microbiology & Life Sciences - Apply Now
This job position has been filled
Officer - R&D
Locations:...
Exciting Young Professional-I Job Opportunity at ICAR-NIANP – Don’t Miss Out!
ICAR-NIANP BSc Biotech Job - Biochem, Agriculture & Life Sciences Apply
ICAR-NATIONAL INSTITUTE OF ANIMAL NUTRITION & PHYSIOLOGY
ADUGODI, BANGALORE – 560 030
PHONE: 080-25711304/25711164; Fax: 080-25711420
Website:...
NIBMG Biological Sciences Job With Rs. 42,000 pm Pay – Apply Online
NIBMG Biological Sciences Job With Rs. 42,000 pm Pay - Apply Online
Advertisement No. NIBMG/ADMIN/ESTB/2024-25/ 088 Date: 11/06/2024
Position available
Project name: “UNDERSTANDING THE ROLE OF PROTEINS...
Exclusive Opportunity For DBT-JRF Fellowship Holders: IISER Kolkata Ph.D. Program in Biological Sciences Autumn...
DBT-JRF Fellowship PhD Program at IISER Kolkata - Attend Walk-In-Interview
Doctor of Philosophy Program (Ph.D.)
Department of Biological Sciences, IISER Kolkata
‘Walk-in-Interview’ for the 2024 DBT-JRF...
Govt National Institute of Biologicals Life Sciences Jobs With up To Rs. 52,000 pm...
Govt Life Sciences Jobs at NIB - Applications Invited
RAJDHANI ENTERPRISES
Head Office: 411, 4th Floor, P.No.389, Leela Ram Market,
Masjid Moth, South Exth.-I New Delhi-110049
Branch Office:...
Biotecnika Times Newsletter 13.06.2024 – Freshers Bioinformatics Jobs, TIFR Mumbai Life Sciences Job, Amity...
Exciting Associate Content Editor Opportunity at Clarivate! Freshers Bioinformatics, Biotech Eligible
Apply for the bioinformatics job opening in content editing. Freshers are welcome.
Exciting Job Opportunity...
NIBMG Integrated MS-PhD August 2024 Admissions, Apply Online
NIBMG Integrated MS-PhD Admissions August 2024 In Biomedical Genomics, Apply Online
NIBMG Integrated MS-PhD Admissions August 2024 In Biomedical Genomics, Apply Online. Interested and eligible...
Life Sciences Non-Med Project Research Job With Rs. 71,000 pm Pay – Attend Walk-In...
Life Sciences Non-Med Project Research Job With Rs. 71,000 pm Pay - Attend Walk-In at Presidency University
Advertisement inviting applications for the position of Fellow/Project...
Exciting Job Opportunity at TIFR – BE, BTech, MSc & MTech Biology, Life Sciences...
TIFR Mumbai Project Recruitment - Life Sciences & Biology Apply Online
TATA INSTITUTE OF FUNDAMENTAL RESEARCH
National Centre of the Government of India for Nuclear...
NIBMG MSc Life Sciences Project Assistant Recruitment – Apply Online
NIBMG MSc Life Sciences Project Assistant Recruitment - Apply Online
Advertisement No. NIBMG/ADMIN/ESTB/PRJ RECTT/2024-25/095
Date: 12-06-2024
Position available
Project name: Evaluation of growth factors and stem cell...